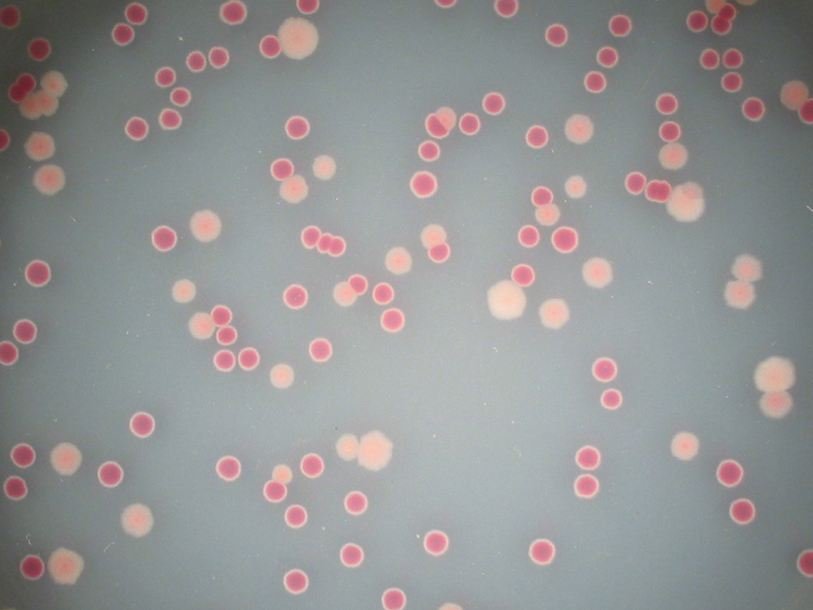

Эволюция не прекращается даже в неизменной окружающей среде
Интеллектуальный партнер проекта Известный американский биолог Ричард Ленски (Richard Lenski), с 1988 года проводящий эксперимент по эволюции кишечной палочки в Университете штата Мичиган (Michigan State University, США) обнародовал новое открытие. В статье, опубликованной в Science, приводятся факты того, что эволюция бактерий, уже приспособившихся к лабораторным условиям, продолжается.
По словам Ленски, пик приспособленности оказался еще более эфемерным понятием, чем было принято считать. В интервью радиостанции WAMC ученый заявил, что, по его мнению, организмы способны повышать свою приспособленность к среде в течение миллионов лет.
Это опровергает распространенную среди биологов позицию, согласно которой организмы достаточно быстро приспосабливаются к новой среде, а затем замирают в своем развитии.
Команда исследователей обнаружила, что пика приспособленности кишечная палочка достигла примерно через 5 лет после начала эксперимента (десятитысячное поколение бактерий). Однако процесс эволюции на этом не остановился. Сейчас, спустя 50 тысяч поколений бактерий, их эволюционирование все еще продолжается.
Ленски собирается и дальше проводить свой эксперимент. При этом он советует каждой микробиологической лаборатории задуматься об экспериментальных исследованиях длиной в пару десятков лет.
Микроорганизмы способны преподносить ученым сюрпризы. Недавно специалисты NASA нашли в стерильных комнатах бактерии, которые могут выдержать даже космическое путешествие.